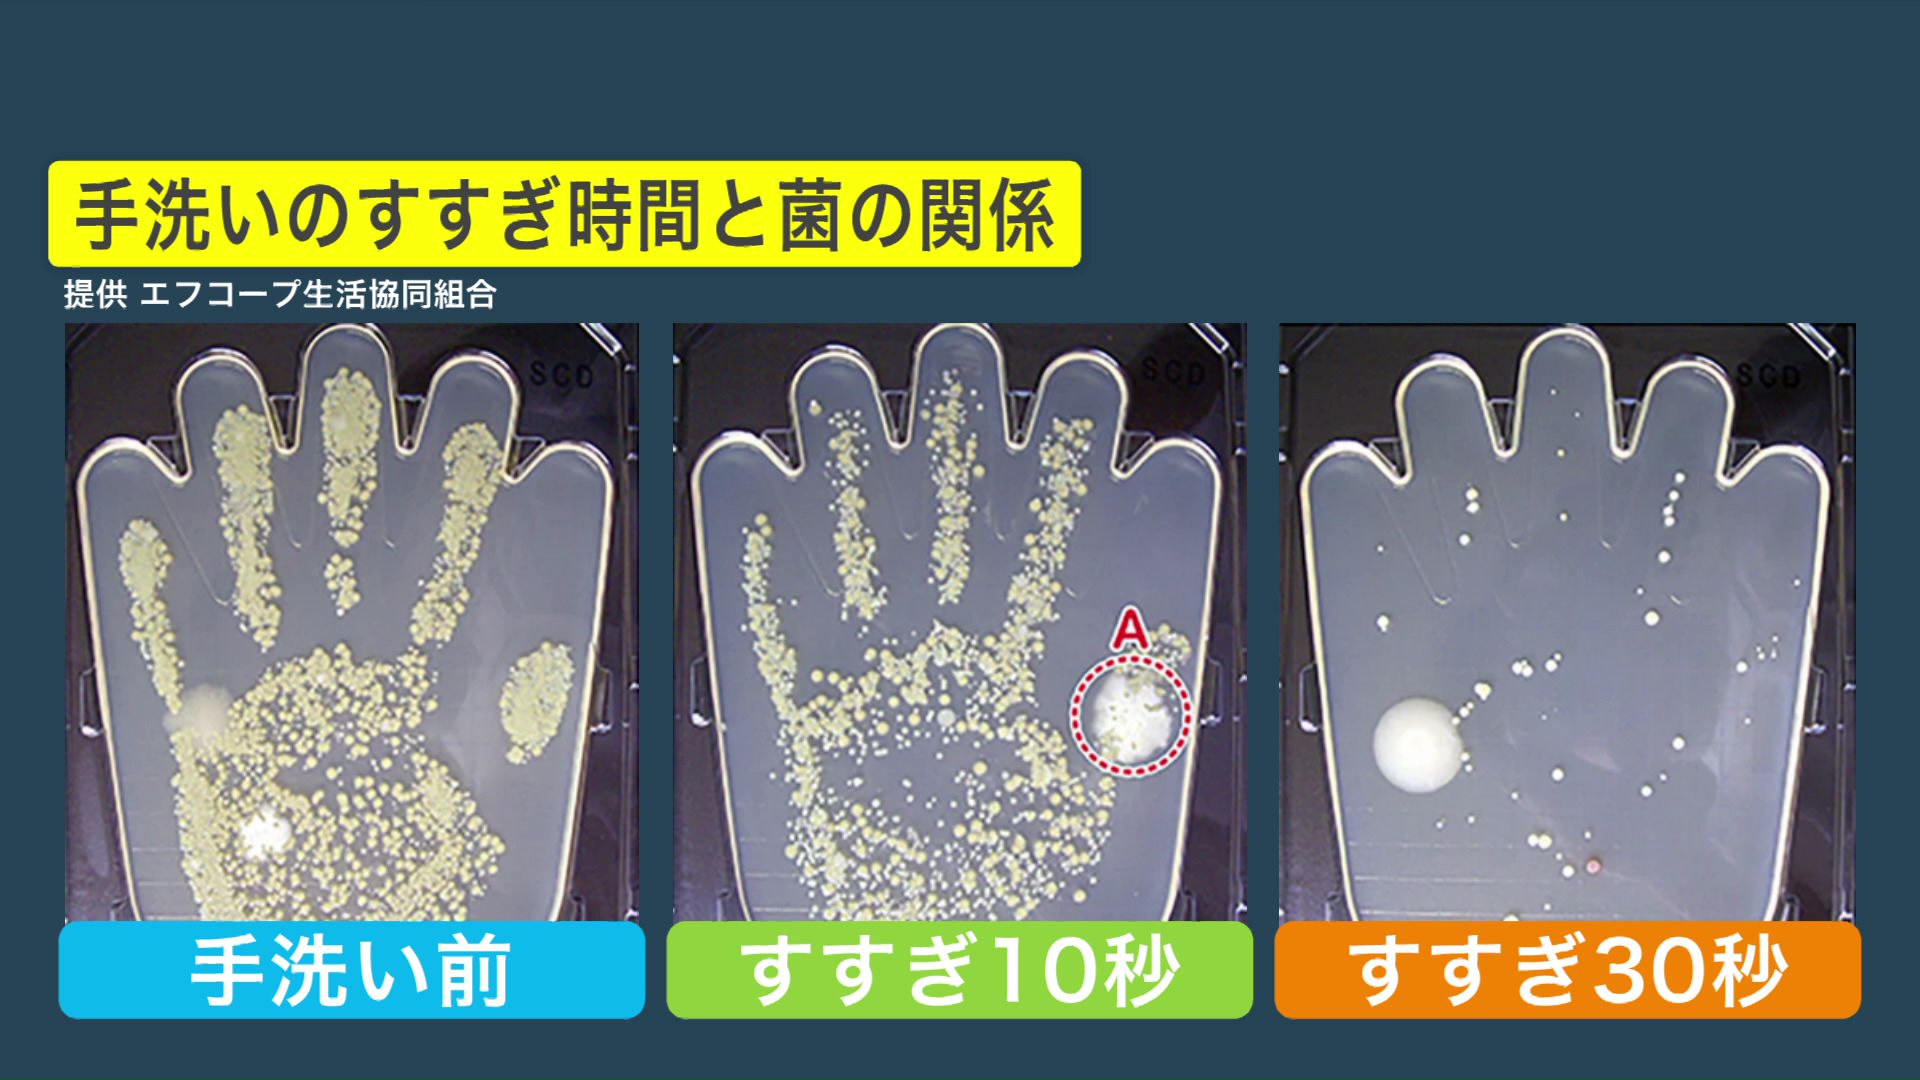

【インフルエンザ流行期】北海道札幌市で「注意報レベル」に…学年閉鎖11校・学級閉鎖34校 感染を防ぐために欠かせない「手洗い」…実は「すすぎの時間」が重要
例年より早くインフルエンザが流行し始めた札幌市。
札幌市の患者数は先週の段階で1医療機関当たり7.98人と「注意報レベル」に近づいており、札幌市立の学校ではすでに学年閉鎖が11校、学級閉鎖が34校に上っています。
札幌市中央区の円山ため小児科でも、今週に入ってから患者が増えてきたといいます。
「やっぱり12月に入って一週目、特に二週目に入ってから急激にインフルエンザの患者さんが増えているという印象は持っています。たぶん、年内は少し増えていくのかなと思っています」(円山ため小児科 多米 淳院長)
こちらの親子は「家庭内感染」しているかもしれないということで受診しました。
「まわりで流行っていて私が先にかかって夫に罹患してしまって、私も夫もとにかく関節が痛いのと高熱。コロナの時よりつらかったかも」(来院した人)
「ちょっと2024年は12月の二週目から増えているので、例年よりは早いのかなという印象です」(多米院長)
インフルエンザの感染を防ぐために欠かせないのが「手洗い」ですが、実は「すすぎの時間」も重要です。
エフコープ生活協同組合によりますと、泡状のハンドソープをつけて15秒間手を洗い、すすぎ時間で菌の状態を検査しました。
10秒ほどすすぐと手に付いたハンドソープが落ち、汚れがしっかり取れたような感覚になります。
しかし、菌の減り方は手を洗う前と大きくは変わりません。
しかも、洗う前にはなかった別の種類の菌が出てくる箇所もあります。一方、すすぎ時間を30秒以上かけると、菌はほぼ洗い流すことができました。
しっかり菌を洗い落とすために30秒以上、すすぎ時間を取るよう心がけましょう。
多米院長は基本的な感染対策をした上で、これから本格的に流行拡大する前にワクチンを打つことも1つの手だということです。
「ワクチンを接種して二週間後から効果が出るので、本当のピークの1月下旬から2月まで時間的余裕がありますので希望する人は年内に打って頂くということが予防、軽症化につながる」(多米院長)